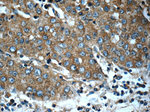
OAS2 Antibody in Immunohistochemistry (Paraffin) (IHC (P))

Search
Proteintech
OAS2 Polyclonal Antibody
{{$productOrderCtrl.translations['antibody.pdp.commerceCard.promotion.promotions']}}
{{$productOrderCtrl.translations['antibody.pdp.commerceCard.promotion.viewpromo']}}
{{$productOrderCtrl.translations['antibody.pdp.commerceCard.promotion.promocode']}}: {{promo.promoCode}} {{promo.promoTitle}} {{promo.promoDescription}}. {{$productOrderCtrl.translations['antibody.pdp.commerceCard.promotion.learnmore']}}
产品信息
19279-1-AP
种属反应
已发表种属
宿主/亚型
分类
类型
抗原
偶联物
形式
浓度
规格
纯化类型
保存液
内含物
保存条件
运输条件
产品详细信息
This antibody is specific to isoform p71 and isoform p69 of OAS2.
Immunogen sequence: NVLPAPLFT TPGHLLDKFI KEFLQPNKCF LEQIDSAVNI IRTFLKENCF RQSTAKIQIV RGGSTAKGTA LKTGSDADLV VFHNSLKSYT SQKNERHKIV KEIHEQLKAF WREKEEELEV SFEPPKWKAP RVLSFSLKSK VLNESVSFDV LPAFNALGQL SSGSTPSPEV YAGLIDLYKS SDLPGGEFST CFTVLQRNFI RSRPTKLKDL IRLVKHWYKE CERKLKPKGS LPPKYALELL TIYAWEQGSG VPDFDTAEGF RTVLELVTQY QQLCIFWKVN YNFEDETVRK FLLSQLQKTR PVILDPAEPT GDVGGGDRWC WHLLAKEAKE WLSSPCFKDG TGNPIPPWKV PVKVI (334-687 aa encoded by BC049215)
靶标信息
This gene encodes a member of the 2-5A synthetase family, essential proteins involved in the innate immune response to viral infection. The encoded protein is induced by interferons and uses adenosine triphosphate in 2'-specific nucleotidyl transfer reactions to synthesize 2',5'-oligoadenylates. These molecules activate latent RNase L, which results in viral RNA degradation and the inhibition of viral replication. The three known members of this gene family are located in a cluster on chromosome 12. Alternatively spliced transcript variants encoding different isoforms have been described.
仅用于科研。不用于诊断过程。未经明确授权不得转售。
生物信息学
蛋白别名: (2'-5')oligo(A) synthetase 2; (2-5')oligo(A) synthase 2; 2'-5'-oligoadenylate synthase 2; 2'-5'-oligoadenylate synthetase 2, 69/71kDa; 2-5A synthase 2; A synthetase 2; MGC78578; p69 OAS / p71 OAS; p69OAS / p71OAS; unnamed protein product
基因别名: OAS2
UniProt ID: (Human) P29728
Entrez Gene ID: (Human) 4939